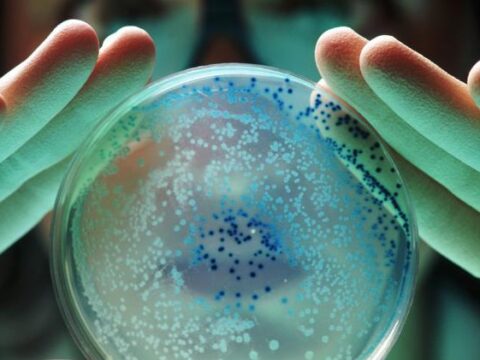

Etiqueta: bacterias
Advierten efecto de cambio climático en mayor presencia de bacterias
Investigadores advirtieron del aumento del Vibrio, bacterias acuáticas que habitan en los mariscos debido al cambio climático, por lo que se cree que los casos…
Descubren en el mar de Japón bacterias resistentes a las heladas que ‘comen’ el petróleo
Los científicos de la Universidad Federal del Lejano Oriente (UFLO) en la ciudad rusa de Vladivostok hallaron en el mar de Japón bacterias resistentes a…
OMS advierte de una “pandemia silenciosa” causada por bacterias resistentes
Un nuevo análisis de la Organización Mundial de la Salud (OMS) advierte sobre una “pandemia silenciosa” causada por bacterias resistentes a los medicamentos debido a…
La OMS identifica las enfermedades más peligrosas que amenazan el planeta en 2023
Más de 300 científicos examinarán las pruebas sobre más de 25 familias de virus y de bacterias, incluida la “enfermedad X”, referida a un patógeno…
Hallan cientos de bacterias desconocidas en los glaciares tibetanos
Investigadores de la Universidad de la Academia de Ciencias de China extrajeron muestras de los glaciares de la meseta tibetana y descubrieron que allí había…